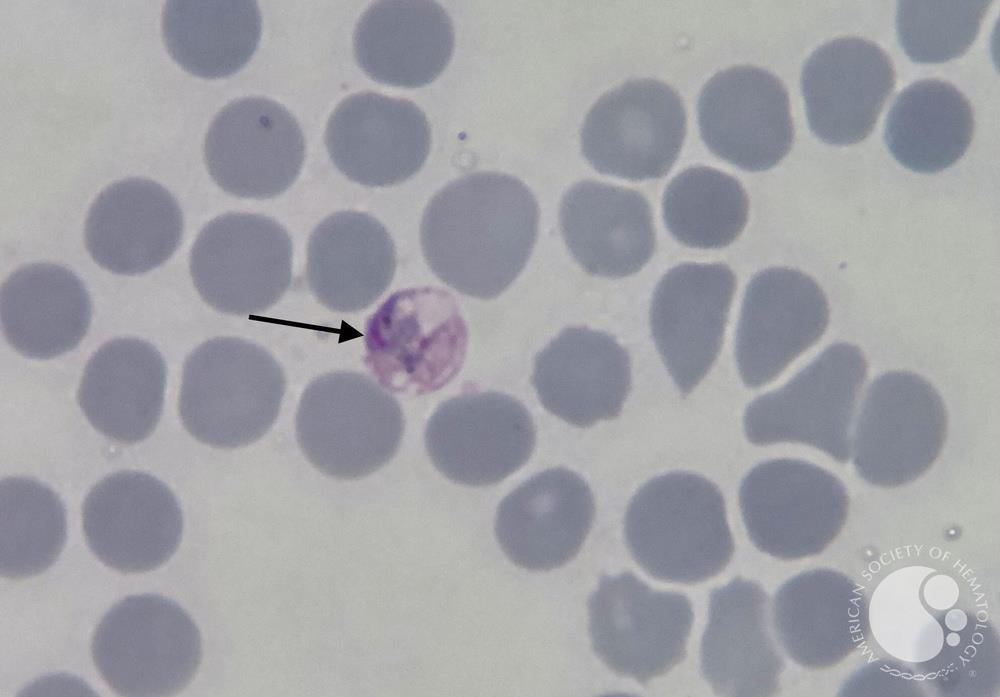
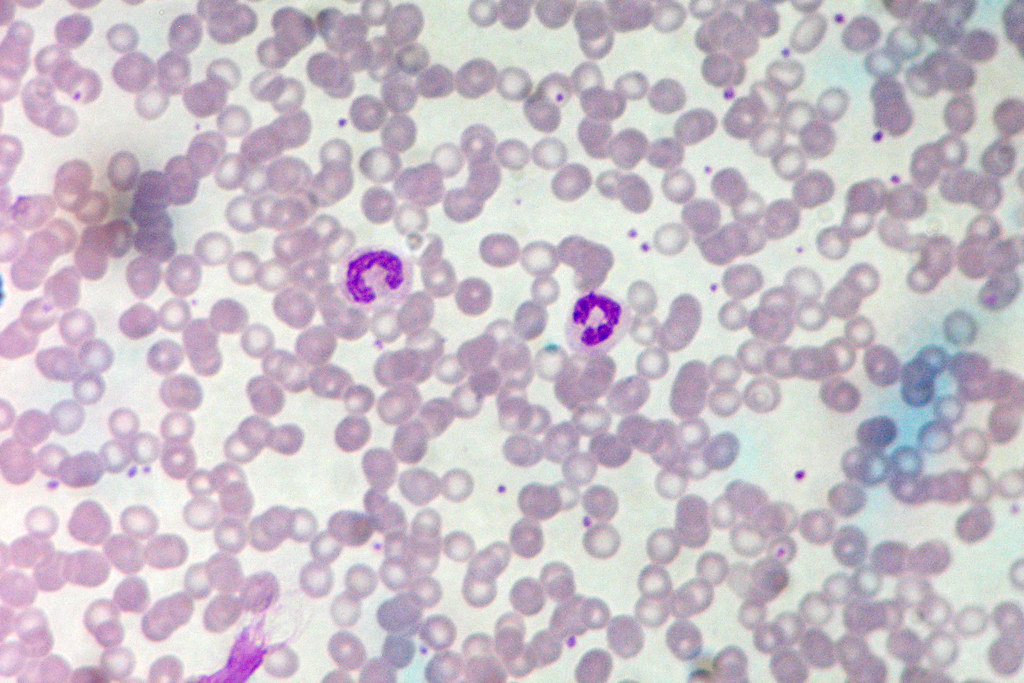

Microscopy Lab Organisms
Use this as a guide to know what to look for when observing the microscopic specimens during your lab.
Streptococcus pneumoniae



Paramecium caudatum



E. coli


Euglena gracilis



Plasmodium vivax

Staphylococcus aureus



Bacillus anthracis



Corynbacterium diptheriae



Arcyria capillitium


Ectocarpus (plurilocular)


